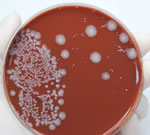

отказ почек симптомы
Популярные статьи на тему: отказ почек симптомы

Для лечения гипертензии при заболеваниях почек предложен целый ряд рекомендаций, основанных на данных доказательной медицины: руководства Американской JNC-VII (05.2003), Европейской ESH/ESC (06.2003), Британской BHS-IV (04.2004), Американской АНА...

Продолжение. Начало в № 80 Продолжение в № 81. Мы сформировали «портрет» больного органической ацидурией (ОА): наиболее важным признаком было отсутствие точного диагноза, который бы объяснял рецидивирующие симптомы. Отмечалась...

Кровь в моче – это симптом, который требует скорейшего установления причины гематурии, как называют это явление врачи. Гематурия является не самостоятельным заболеванием, а лишь признаком того, что в организме имеется какое-то заболевание.

Цистит - воспалительное заболевание мочевого пузыря - болезнь широко распространенная и очень неприятная, прежде всего из-за симптомов, таких как боль и дискомфорт, а также в связи со склонностью к переходу в хроническую форму.

Криптококкоз (легочный, системный торулез, европейский бластомикоз, болезнь Буссе-Бушке) – подострая или хроническая инфекция, вызываемая дрожжеподобным микромицетом Cryptococcus neoformans.

Болезнь Крона – хроническое рецидивирующее заболевание, специфической особенностью которого является сегментарное трансмуральное гранулематозное воспаление любого отдела пищевого канала от полости рта до ануса.

Темой очередного заседания неврологического общества г. Киева стала одна из наиболее насущных проблем неврологии и медицины в целом – вторичная профилактика инсульта.

Мы продолжаем публикацию материалов, подготовленных по мотивам одного из интереснейших медицинских событий года – VII Зимней школы врачей-интернистов, организованной при поддержке известной фармацевтической компании «Рихтер Гедеон».

В основу алгоритма по ведению больных с хронической ИБС легли созданные и обновленные в 2006 году рекомендации Американской коллегии кардиологов и Американской ассоциации сердца по вторичной профилактике.
Новости на тему: отказ почек симптомы

Привычка многих современных людей питаться «на ходу», тем более едой из кафе фастфуда, повышает риск развития изжоги. В аптеках есть сотни препаратов, устраняющих неприятные симптомы, но многие такие лекарства обладают опасным побочным действием.

Когда Тому Хиггсу было 7 лет, жизнь маленького мальчика оказалась в серьезной опасности – из-за редкого заболевания у него отказали почки. Несколько лет его жизнь поддерживалась только благодаря гемодиализу – но затем Том встретил доброго волшебника.
В одном из немецких городов власти вынуждены были закрыть школу, после того как сразу у нескольких учеников появились симптомы заболевания, вызываемого смертельно опасным штаммом кишечной палочки. А общее число ее жертв в стране приближается к 50.

В конце минувшей недели французские врачи забили тревогу: сразу шестеро детей из города Лилль были госпитализированы после появления характерных симптомов заражения кишечной палочкой. Бактерия, к счастью, оказалась не убийственным штаммом О104.

Не прошло и недели с того момента как Минздрав Мали объявил о том, что местным медикам удалось предотвратить вспышку вирусной лихорадки Эбола, как ситуация резко изменилась. Оказалось, что как минимум 3 случая заболевания не были распознаны вовремя.

Новый коронавирус захватил инициативу и стал выигрывать в смертельном соревновании – в минувший уикенд стало известно о новой смерти от атипичной пневмонии. Таким образом счет стал 7:6 в пользу вируса. Начат поиск потенциальных жертв.

Случай, когда в американской детской больнице центра Джона Хопкинса свиным гриппом заболело 13 детей, многому научил специалистов. Хотя все юные пациенты остались живы, заболевание протекало тяжело, а осложнения развивались стремительно, непредсказуемо, и были разнообразными. Для спасения больных от врачей требовались пристальный мониторинг и мгновенная реакция.
